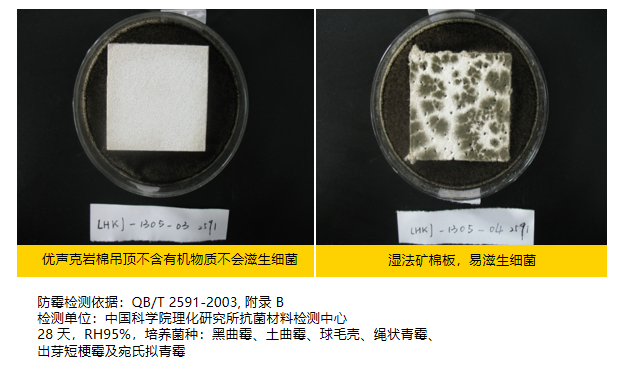

独家揭秘!优声克岩棉吸音吊顶:打造静谧空间的声学魔法
2024/06/07
随着社会的发展和科技的进步,吸音面板在高端建材领域中扮演着越来越重要的角色。晋强实业致力于成为华东地区极具专业的建筑板材供应商之一,在新材料事业部全体同事的努力下,积极为优声客岩棉吸音吊顶开拓高端吸音建材领域的市场,积累了诸多成熟案例。
实力雄厚 性能优良
优声克(Eurocoustic)隶属于全球财富五百强企业之一、世界建材百强排名首位的法国圣戈班,是该跨国集团旗下一家专业生产岩棉吊顶及墙板的全资子公司,生产总部位于法国克勒兹省的热努亚克。

作为设计与生产高性能吸音天花的先驱者,优声克以专业的室内声学矫正、吸音隔音、防火防潮解决方案享誉全球,致力于以一流的产品与服务升级建筑项目舒适度。
优声克岩棉取材于火山岩,100%可循环再利用

优声克岩棉不仅在打造静谧环境、改善室内音质上表现出色,更凭借欧标A级的高防火性能切实保护居住者的人身财产安全。

优声克岩棉丝里有很多微孔,声波在里面来回穿梭与摩擦,最后声能转化成热能消耗掉。优声克吊顶NRC 值最低0.9,大部分1.0

优声克依靠岩棉材料的高憎水性,保证产品在不同情况下尺寸依旧稳定,尤其在湿度极高的情境中不变形。
设计自由 应用广泛
2014年,晋强实业携手法国优声克登陆中国高端建材市场,推广岩棉这一新型天然环保材料,受到追求高品质生活及环保人士的关注和推崇。

截至目前,优声克已成功为国内百余个建筑项目提供专业的吸音吊顶解决方案,赢得广大客户的信赖,在业界树立了良好的口碑。



优声克·声学空间上新!

郑州银行成立于1996年,2015年、2018年先后在香港、深圳上市,是河南省首家A股上市银行、国内首家A+H上市城商行,2022年4月被河南省委、省政府确定为河南省政策性科创金融运营主体。
为了更好地展示银行形象,塑造更为高端和专业的公司品牌,郑州银行在改造过程中为金融服务中心安装了优声克岩棉吸音吊顶。



优声克岩棉吸音吊顶是通过合理的应用结构和适当的密度选择,可以在建筑项目中发挥重要的隔音作用,提高室内舒适度。





优声克针对不同类型的建筑项目,推出兼顾通用与个性化的产品选择,力求灵活应对影响室内舒适度的多种因素,为您量身打造一款理想的岩棉吊顶产品。未来,晋强实业继续与优声克开展深度合作,携手共赢!

